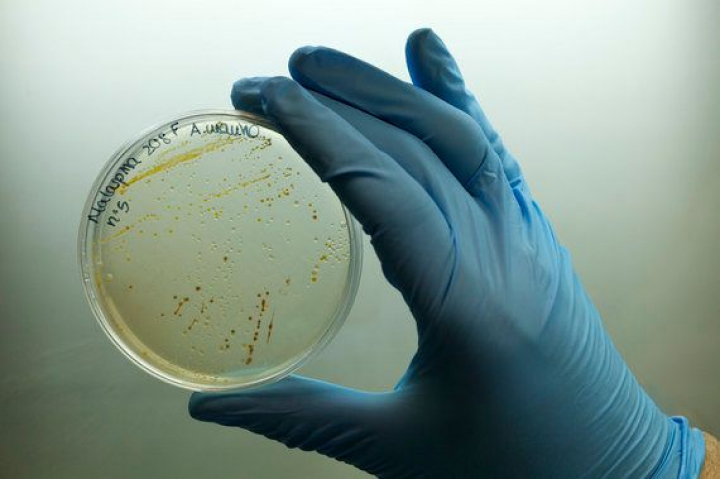

El Genoma de la Biosfera ha de ser Patrimonio de la Humanidad
En 2010 había mas de 5.000 genes de organismos marinos patentados y los derechos de propiedad intelectual por su uso reportaban más de 9.000 millones de euros anuales de beneficios, con este mercado creciendo a un 12% anual. Entre estos países se encuentra Suiza, que no tiene costa.
El miércoles 12 de junio presentábamos en la sede del CSIC en Madrid los primeros resultados del proyecto Malaspinomics, que ha iniciado la secuenciación del genoma del océano global a partir de la colección de muestras recogidas durante la Expedición Malaspina 2010, que coordino.
El jueves, el tribunal Supremo de EEUU dictaminaba que el ADN natural no puede ser patentado, declarando así inválidas dos patentes sobre genes humanos usados en kits de diagnóstico de cáncer.
Aunque no lo parezca estas dos noticias tienen mucho en común y suponen la convergencia de un recorrido que iniciamos hace más de 6 años.
Uno de los objetivos centrales de la Expedición Malaspina 2010 era impulsar la exploración de la biodiversidad marina, con énfasis particular en el océano profundo, el mayor ecosistema del planeta y el más desconocido. Las nuevas herramientas de la genómica nos permiten acelerar este proceso, descubriendo a la vez nuevas especies y nuevas funciones.

Fotomontaje de fotos de Joan Costa para el proyecto Malaspinomics. Photo: Joan Costa, Expedicion Malaspina 2010.
Uno de los problemas con que nos encontramos cuando diseñábamos la propuesta de Expedición Malaspina 2010 era que nuestro objetivo de utilizar técnicas de secuenciación masiva para impulsar el avance en nuestro conocimiento de la biodiversidad y funcionamiento del ecosistema del océano profundo parecía irrealizable. Esto era así por tres razones, en primer lugar el coste de secuenciación que deberíamos presupuestar en 2007, cuando preparábamos la propuesta, era de 5.000 millones de euros, cuando el presupuesto máximo que permitía la convocatoria era de 5 millones de euros (al final obtuvimos 4,2 millones de euros). Además, no existía en España ninguna plataforma de secuenciación genómica con capacidad suficiente. Finalmente, la cantidad de muestra de océano profundo que podíamos obtener, que por razones operativas se fijaba en un máximo de 240 litros de agua por muestra, no contenía suficiente ADN para permitir su secuenciación.
Confiábamos en que estos dos problemas se resolverían, así que arriesgamos y recogimos muestras para análisis genómicos sin presupuesto para llevarlo a cabo. La Colección Malaspinomics es la primera colección global de genoma del océano, pues los otros dos proyectos globales existentes (la expedición Sorcerer II de Craig Venter y la expedición TaraOceans, con quienes colaboramos) solo pudieron obtener muestras del océano superficial, mientras que la Colección Malaspinomics se extiende desde la superficie del océano hasta 4.000 metros de profundidad.
Asumir riesgos es imprescindible para realizar investigación de frontera, como es la de la Expedición Malaspina 2010. Esta vez hemos sorteado estos riesgos con éxito, porque desde 2007 hasta 2013, cuando hemos iniciado la secuenciación de las muestras recogidas durante la expedición, el coste de secuenciación ha caído más de 4.000 veces, desde 400 euros hasta 0,10 euros por millón de par de bases de ADN secuenciado. Además el Gobierno decidió crear, junto a otros socios, el Centro Nacional de Análisis Genómico en Barcelona, en el que invirtió 30 millones de euros para dotarlo de la tecnología más avanzada. Estas nuevas tecnologías permiten, además, la secuenciación de la cantidad de ADN de la que disponíamos en nuestras muestras.

Presentación del proyecto Malaspinomics a los medios. De izquierda a dcha: Josep M. Gasol (CSIC), Carmen Vela (secretaria de Estado de Investigación, Desarrollo e Innovación), Emilio Lora Tamayo (presidente del CSIC), y Carlos M. Duarte (CSIC). Photo: Joan Costa, Expedicion Malaspina 2010.
Pero había una tercera cuestión que nos preocupaba. Sabíamos que encontraríamos genes que tendrían aplicaciones para resolver problemas en un rango amplio de sectores de biotecnología, incluyendo farmacia, cosmética, alimentación y energía, entre otros. Ejemplos pasados indicaban que era importante proteger estos descubrimientos, porque si no vendrían otros y lo harían, como ha ocurrido ya numerosas veces, aprovechándose de nuestra investigación para enriquecerse. Pero eso suponía patentar genes, lo que nos planteaba problemas éticos importantes que considerábamos no resueltos.
Así que nos propusimos investigar qué requisitos ponen las oficinas de patentes para patentar genes, cuántos genes marinos se han patentados y qué valor generan. Para nuestra sorpresa encontramos que las oficinas de patentes solo requieren que se describa la secuencia (de bases) de un gen y la función que desempeña. No era necesario ni declarar el organismo del que se habían secuenciado ni de dónde se había obtenido este organismo. Esto nos pareció inadmisible y una invitación clara a la biopiratería. Además, averiguamos que en 2010 había mas de 5.000 genes de organismos marinos patentados y que los derechos de propiedad intelectual por su uso reportaban más de 9.000 millones de euros anuales de beneficios, con este mercado creciendo a un 12% anual.
Muestra de la colección Malaspinomics. Photo: Joan Costa, Expedicion Malaspina 2010.
Cruzando bases de datos y con un esfuerzo de programación que a punto estuvo de quemar el ordenador de Txetxu Arrieta, uno de mis colaboradores en este trabajo, encontramos que los 3 países con mayor número de patentes de genes marinos acaparaban más del 70 % de las patentes, y que los 10 países con mayor número de patentes acaparaban el 90 % de todas las patentes. Es significativo que entre estos países se encuentra Suiza, país que no tiene costa y para el que la pregunta de dónde se habían obtenido esos genes marinos era aún más relevante. Además, parece haber un mercado secundario de compra-venta de estas patentes, que estamos investigando ahora, que lleva a una concentración aún mayor de este recurso.
En el artículo, publicado en la revista Science, donde dábamos cuenta de estos resultados, advertíamos que esta misma acaparación de patentes de genes por unos pocos países tecnológicamente avanzados se daba también para los genes humanos patentados (más de 40.000) y los de plantas y animales de interés agrícola. Además argumentábamos que los genes no debieran poderse patentar, porque no son fruto de la invención sino de la evolución, y los científicos simplemente los describimos. Estos argumentos son los mismos que han llevado al Tribunal Supremo de Estados Unidos a dictaminar que los genes no se pueden patentar.
Propusimos, para resolver esta cuestión la creación de una autoridad, bajo Naciones Unidas, que gestionase el genoma de todas las especies, incluida la nuestra, como patrimonio de la humanidad. Esta autoridad aseguraría que los beneficios permanecen accesibles a toda la humanidad a la vez que un retorno justo para quienes han hecho los descubrimientos.

Secuenciación de genoma del océano profundo en el Centro Nacional de Genómica. Photo: Joan Costa, Expedicion Malaspina 2010.
Nuestra propuesta se ha venido discutiendo en el marco de un grupo de trabajo de La Ley del Mar de Naciones Unidas que poco a poco ha ganado impulso, con lo que pensamos que dentro de poco será realidad. La decisión del Tribunal Supremo de EEUU, que asume nuestros argumentos, podría acelerar este proceso, por lo que mis compañeros en esta investigación y yo estamos muy satisfechos.
Pero volvamos al programa Malaspinomics de secuenciación del genoma del océano global. El programa Malaspinomics ha arrancado gracias a una ayuda concedida por el Ministerio de Economía y Competitividad (MINECO) este año, con el liderazgo de los investigadores del CSIC Josep M. Gasol, Silvia Acinas y Txetxu Arrieta y con la participación clave del Centro Nacional de Análisis Genómico. Así que el genoma del océano global se está secuenciando por primera vez y este hito en la exploración del océano es está llevando a cabo en España, de lo que todos debiéramos felicitarnos. Por recomendación de los evaluadores, el MINECO nos concedió financiación para un solo año, por una tercera parte de la cantidad que solicitábamos, pues consideraban, con buen criterio, que debíamos demostrar la viabilidad de llevar a cabo esta secuenciación antes de recibir el 100% de la financiación necesaria.
Afortunadamente, ya hemos superado esta prueba y demostrado la viabilidad de Malaspinomics con lo que los responsables de este proyecto estamos muy satisfechos. Los resultados obtenidos hasta ahora así lo justifican, porque revelan que el 80% de las especies microbianas del océano profundo detectadas mediante técnicas de secuenciación masiva son desconocidas y que un 86% de los genes que llevamos detectados, y que podrían llegar a superar decenas de millones cuando completemos el proyecto, eran desconocidos hasta ahora. Entre los genes conocidos nos ha sorprendido encontrar genes que codifican proteínas implicadas en la degradación de compuestos altamente tóxicos como metilmercurio, aflatoxinas y dioxinas derivados de la actividad humana.
En un par de años esperamos haber avanzado suficientemente como para empezar a explorar el potencial biotecnológico del genoma del océano profundo. Para entonces, esperamos que nuestra propuesta de un mecanismo de gobernanza del genoma global en beneficio de la humanidad sea ya una realidad.
Corren tiempos muy difíciles, yo diría críticos, para la ciencia española, pero a pesar de las dificultades aún somos capaces de liderar grandes retos científicos. La oceanografía española está tocada, pero no hundida. No bajemos los brazos ni nos demos por venidos. Saldremos de esta a través de la cooperación entre todos y el apoyo de la sociedad, que valora la ciencia y con quien hemos de compartirla.
